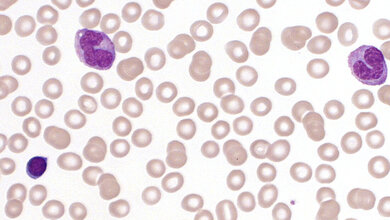
Mikroskopaufnahme von Stammzellen

Eine neue Studie von Forscherinnen und Forschern des Center for Genomic Regulation und vom Institute for Research in Biomedicine, beide Barcelona, sowie vom DKFZ erklärt, wie Alterung das Blutsystem umgestaltet. Sowohl bei Menschen als auch bei Mäusen verdrängen demnach einige wenige Stammzellklone ihre Nachbarn und übernehmen nach und nach die Blutproduktion. Das Reservoir an Blutstammzellen schrumpft und wird von Klonen dominiert, die eine Vorliebe für die Produktion von myeloischen Zellen haben, also Immunzellen, die mit chronischen Entzündungen in Verbindung stehen. Frühere Studien an Mäusen hatten gezeigt, dass die selektive Entfernung myeloisch prädominanter Stammzellen ein jüngeres Profil der Blutstammzellen wiederherstellen, die Produktion von infektionsbekämpfenden Lymphozyten ankurbeln und die Immunantwort verbessern kann.
Nachweisbar schon ab 50 Jahren
Die Veränderungen waren bereits im Alter von 50 Jahren nachweisbar. Im Alter von 60 Jahren wurden sie bei fast allen Probanden beobachtet. Die Autoren der Studie vermuten, dass der Verlust der Klonvielfalt dazu beitragen kann, das „Inflammaging“ zu erklären, die anhaltende chronische Entzündung, die im Alter auftritt und uns anfälliger für Krankheiten machen kann. Das Team beobachtete dieses Muster sowohl bei Mäusen als auch bei Menschen. Das deute darauf hin, dass die Ergebnisse ein grundlegendes Merkmal der Blutalterung bei verschiedenen Spezies sind.
Frühwarnzeichen für ungesunde Alterung?
Die Arbeit könnte zu neuen Strategien führen, mit denen Frühwarnzeichen für ungesunde Alterung lange vor dem Auftreten von Symptomen erkannt werden könnten, um so Krankheiten wie Krebs oder Immunerkrankungen vorzubeugen. Sie eröffne auch Möglichkeiten zur Untersuchung der Wirksamkeit von Verjüngungstherapien beim Menschen, die bisher vor allem an Tieren untersucht wurden. „Unsere Blutstammzellen konkurrieren ums Überleben. In der Jugend entsteht durch diesen Wettbewerb ein reichhaltiges, vielfältiges Ökosystem, während im Alter einige vollständig ausfallen. Einige wenige Stammzellen übernehmen die Kontrolle und arbeiten besonders hart, um dies auszugleichen. Dadurch verringert sich die Vielfalt, was sich negativ auf die Widerstandsfähigkeit des Blutsystems auswirkt. Vielfältige Stammzellen können auf unterschiedliche Belastungen reagieren, sodass die Dominanz einer Handvoll Klone das gesamte System anfälliger macht“, erklärt Lars Velten, Gruppenleiter am Centre for Genomic Regulation (CRG) in Barcelona und einer der Studienleiter.
Konzentration auf Epimutationen
In jungen Jahren besitzt jeder Mensch zwischen 50.000 und 200.000 aktive Blutstammzellen, die täglich zwischen 100 und 200 Milliarden neue Blutzellen bilden. Das Team konzentrierte sich in der aktuellen Arbeit auf die Epimutationen. Dabei handelt es sich um Veränderungen der chemischen Markierungen an der DNA, auch DNA Methylierung genannt. Sie hinterlassen einen permanenten, natürlichen „Barcode“, den Forscher auslesen können, um die Position jeder Zelle im Stammbaum zu bestimmen. „Unsere Zellen tragen genetische Veränderungen, die uns zu einzigartigen Individuen machen. Aber wir sind auch ein Mosaik aus epigenetischen Veränderungen. Gruppen von Zellen, auch wenn sie letztendlich unterschiedliche Aufgaben erfüllen, tragen Methylierungs-Barcodes, die sie mit einer gemeinsamen Vorläuferstammzelle verbinden. Wir sind endlich in der Lage, den epigenetischen Stammbaum zu erstellen, indem wir Informationen lesen, die direkt in die DNA jeder Zelle geschrieben sind“, sagt Alejo Rodriguez-Fraticelli, ebenfalls einer der Studienleiter.
Einsatz neuer Technik namens EPI-Clone
Die Forscher entwickelten eine neue Technik namens EPI-Clone, mit der Methylierungs-Barcodes einzelner Zellen gelesen werden können. Mit ihrer Hilfe rekonstruierten sie die Geschichte der Blutbildung bei Mäusen und Menschen und konnten so nachvollziehen, welche Stammzellen zur Blutbildung beitrugen und welche im Laufe der Zeit aus dem Rennen ausgeschieden waren. „DNA-Methylierung funktioniert wie eine Art Binärcode. An jeder Position im Genom ist eine Stelle entweder methyliert oder nicht, wie eine 1 oder eine 0“, erklärt Michael Scherer, Bioinformatiker und Co-Erstautor der Studie, der die Arbeit am CRG leitete und nun am Deutschen Krebsforschungszentrum (DKFZ) forscht. „Diese einfache On-Off-Information kann in einen natürlichen Barcode umgewandelt werden, den jede Stammzelle an ihre Nachkommen weitergibt. Vor fünf Jahren hätte ich eine solche Auflösung auf Einzelzellniveau und bei Zehntausenden von Zellen nicht für möglich gehalten. Das ist ein enormer technologischer Fortschritt“, fügt Scherer hinzu.
Größere Klone gewinnen die Oberhand
In jungem Blut trugen Tausende verschiedener Stammzellen zu einem reichen und vielfältigen Pool an roten und weißen Blutkörperchen sowie Blutplättchen bei. EPI-Clone habe jedoch gezeigt, dass bei älteren Mäusen bis zu 70 Prozent der Blutstammzellen zu nur wenigen Dutzend großen Klonen gehörten, verglichen mit etwa 50 Prozent bei jüngeren Mäusen. Bei Menschen sei das Bild ähnlich, obwohl der genaue Prozentsatz bei den zwölf gesunden Spendern (Alter zwischen 35 und 70 Jahre), die an der Studie teilnahmen, variiert habe. Die Forschenden zeigten, dass mit 50 Jahren viele Blutstammzellen zu verschwinden beginnen und größere Klone die Oberhand gewinnen, während sich dieser Wandel mit 60 Jahren und später noch deutlicher abzeichne.
Allgemeines Merkmal alternder Blutzellen?
„Der Wechsel von Vielfalt zu Dominanz ist nicht zufällig, sondern erfolgt wie ein Uhrwerk“, sagt Indranil Singh, Co-Erstautor der Studie und Doktorand am IRB Barcelona. „Mit 50 kann man bereits sehen, wie es beginnt, und nach 60 ist es fast unvermeidlich.“ Die Studie ergab auch, dass einige Stammzellklone Mutationen aufwiesen, die mit der klonalen Hämatopoese in Verbindung stehen, einem Prozess, bei dem einige Blutstammzellen Mutationen erwerben, die ihnen ein schnelleres Wachstum und eine schnellere Vermehrung ermöglichen als anderen. Dieses Phänomen tritt mit zunehmendem Alter häufiger auf und erhöht nachweislich das Risiko für Herzerkrankungen, Schlaganfälle und Leukämie. Viele der von EPI-Clone identifizierten dominanten Klone wiesen jedoch überhaupt keine bekannten Mutationen auf, was darauf hindeutet, dass die klonale Expansion ein allgemeines Merkmal alternder Blutzellen ist.
Klone zur Früherkennung nutzen?
Ärzte könnten eines Tages, nach entsprechender klinischer Forschung, das Verhalten der Klone zur Früherkennung heranziehen. Sie hätten so die Möglichkeit, die Alterung des Blutstammzellpools einer Person zu überwachen - schon Jahre vor eventuellen Ausbruch einer Krankheit. Menschen mit einem schnelleren Verlust der Diversität könnte zu vorbeugenden Maßnahmen geraten werden. Verjüngungstherapien wie sie im Tierversuch bereits umgesetzt wurden, seien beim Menschen derzeit aber noch Zukunftsmusik. Dazu müssten die Forscherinnen und Forscher zunächst identifizieren, welche Klone problematisch sind – was bisher nicht möglich war. EPI-Clone eigne sich für die klinische Forschung, da es mit natürlich vorkommenden Barcodes arbeitet. „Wenn wir über generische Anti-Aging-Behandlungen hinausgehen und zu einer echten Präzisionsmedizin gegen das Altern gelangen wollen, ist dies genau das Werkzeug, das wir brauchen“, sagt Lars Velten. „Wir können nur reparieren, was wir sehen können, und EPI-Clone macht dies zum ersten Mal für den Menschen möglich.“ „Wir haben gezeigt, was möglich ist“, fasst Rodriguez-Fraticelli zusammen. „Jetzt geht es darum, EPI-Clone zu verfeinern, um entsprechende Strategien in der klinischen Forschung zu testen.“
Quelle: DKFZ
Artikel teilen